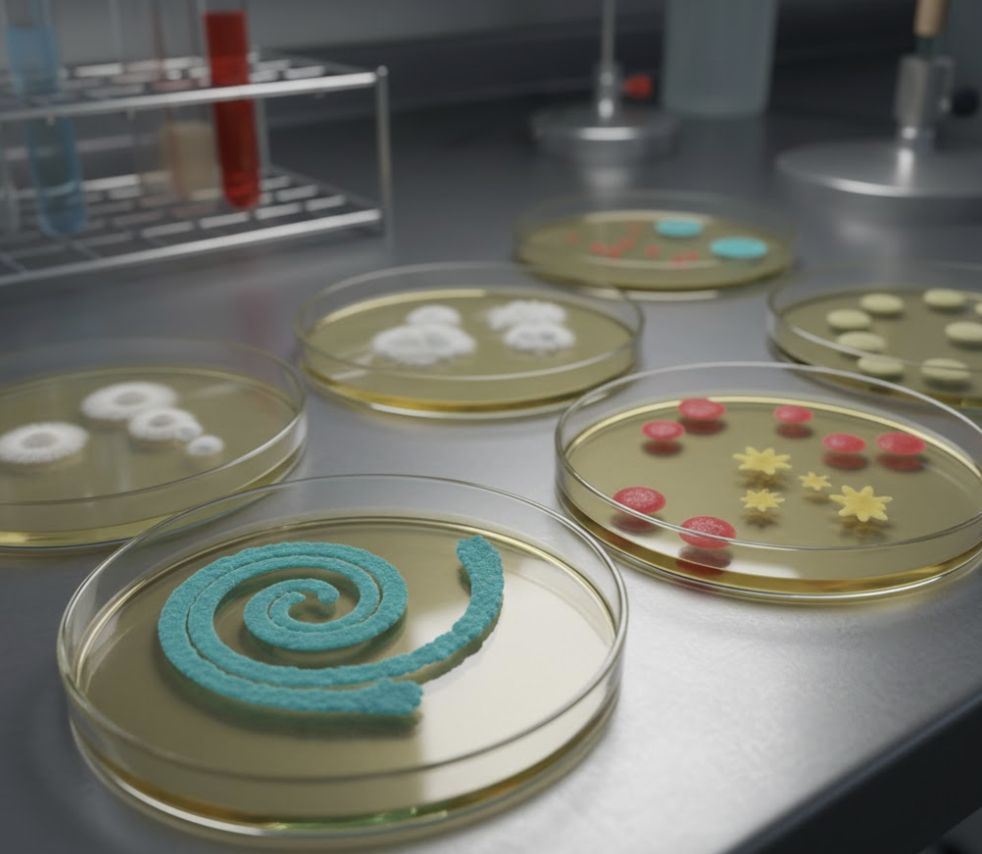
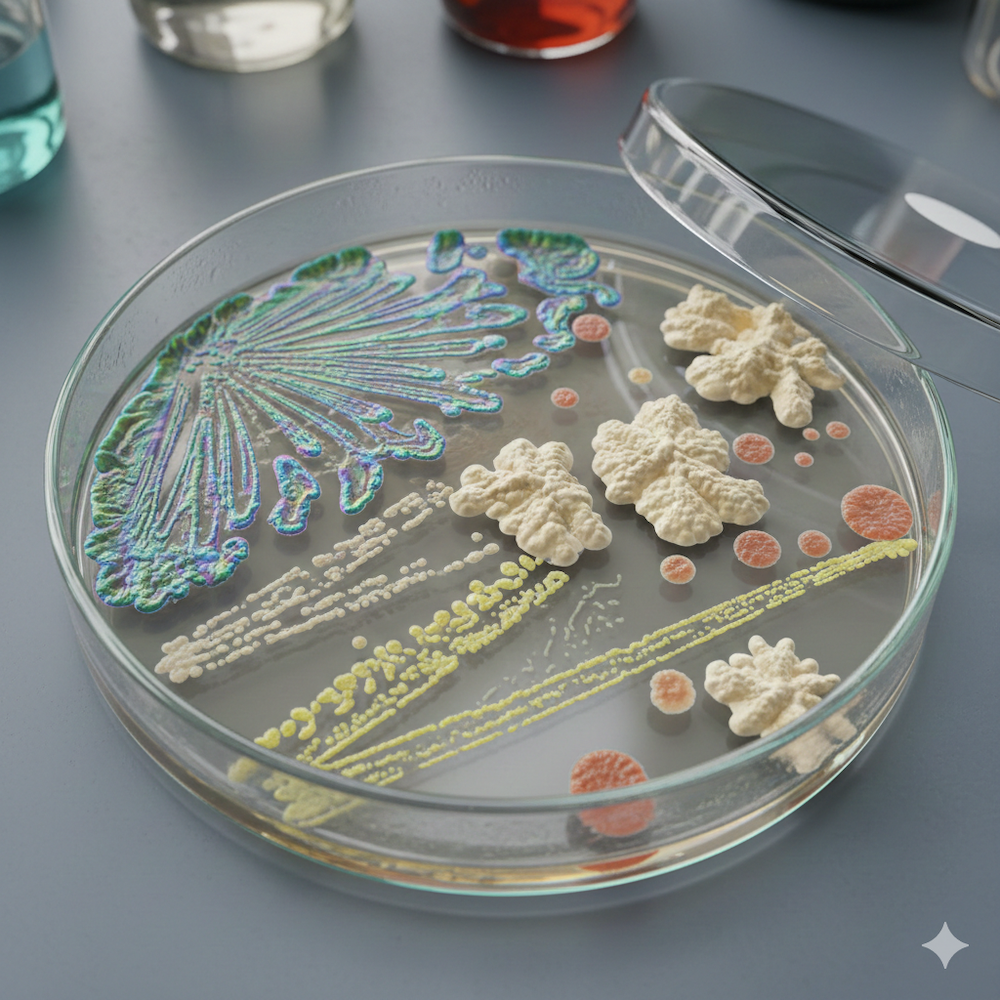

Mikroorganizmi u nama i oko nas
Šta se krije na vrhovima vaših prstiju? Da li znate koliko živih bića upravo sada diše zajedno sa vama?
Pozivamo vas na interaktivnu radionicu koja otvara vrata nevidljivom svetu mikroorganizama: kroz priču, eksperiment i lično iskustvo. Kako izgleda bakterijska ćelija? Zašto bakterije imaju različite oblike? Kada su naši saveznici, a kada uzročnici bolesti? Šta su jednoćelijske gljive i zašto su nezamenljive u poljoprivredi? I najzad: kako se mikroorganizmi gaje u laboratoriji?
U praktičnom delu, učesnici ostavljaju sopstveni „mikrobiološki potpis“ — otiske prstiju na hranljivoj podlozi koje nose kući. Može li kvasac da diše? Kako to dokazati? Šta se zaista vidi pod mikroskopom i kako naučnici beleže ta opažanja? Sve to ćete isprobati sami, uz mikroskopiju i crtanje preparata.
Radionica je osmišljena tako da izazove radoznalost, postavi prava pitanja i pokaže da nauka nije apstraktna — ona je svuda oko nas. I na nama.
O ovoj radionici
Teorija koja pokreće radoznalost
Kako izgleda bakterijska ćelija i zašto postoje različiti oblici bakterija? Kada su bakterije naši saveznici, a kada uzročnici bolesti? Šta su jednoćelijske gljive i kako se koriste u poljoprivredi?
Kroz kratko teoretsko predavanje upoznaćete osnovne principe mikrobiologije — građu bakterijske ćelije, raznovrsnost oblika, ulogu mikroorganizama u prirodi i medicini, kao i tehnike njihovog gajenja u laboratorijskim uslovima.
Šta ćete naučiti?
Teorija je samo početak. Ono što sledi je vaš direktan susret sa mikrobiološkim svetom:
- Laboratorijsko posuđe i oprema: Upoznavanje sa osnovnim laboratorijskim priborom koji koriste mikrobiolozi u svom radu
- Metoda sterilnog rada: Naučite kako se sprečava kontaminacija i zašto je sterilan rad ključan u mikrobiologiji
- Mikrobiološki potpis: Ostavljanje otiska prstiju na hranljivoj podlozi: vaš lični eksperiment koji nosite kući i pratite kako se razvija
- Zasejavanje mikroorganizama: Praktična vežba gajenja bakterija, buđi i mikroorganizama sa ruku na hranljivim podlogama
- Može li kvasac da diše? Vežba sa metaboličkom aktivnošću jednoćelijskih gljiva koja dokazuje da su žive
- Mikroskopiranje: Posmatranje preparata bakterija i gljiva pod mikroskopom
- Crtanje preparata: Naučite kako naučnici beleže svoje opservacije: preciznim crtežom onoga što vide
- Laboratorijski dnevnik: Kako pravilno dokumentovati eksperimente i voditi naučne beleške
O predavaču
Jelena Zagorac je specijalista mikrobiologije sa Biološkog fakulteta Univerziteta u Beogradu. Trenutno je na doktorskim studijama biologije razvića. Predaje biologiju u XII beogradskoj gimanziji. Pored toga, radila je kao saradnik, a sada povremeno kao predavač u Istraživačkoj stanici „Petnica“. Višegodišnji je učesnik sa svojim učenicima na manifestaciji „Noć istraživača“. Njen pristup nastavi zasnovan je na direktnom eksperimentu: učesnici ne posmatraju kako neko drugi radi, već sami postavljaju pitanja, rukuju opremom i dolaze do odgovora kroz praksu.
Za koga je namenjena?
Za sve radoznale — od osnovaca do srednjoškolaca — koji žele da vide šta se zaista krije iza udžbeničkih dijagrama. Nije potrebno predznanje iz mikrobiologije. Sadržaj radionice prilagođen je uzrastu učesnika.
Šta nosite kući?
Svaki učesnik dobija Petri ploču sa sopstvenim otiskom prsta — lični mikrobiološki eksperiment koji nastavlja da se razvija kod kuće. To nije samo suvenir, već način da nastavite da posmatrate i učite i nakon završetka radionice.
Zašto se prijaviti?
Radionica je osmišljena tako da izazove radoznalost, postavi prava pitanja i pokaže da nauka nije apstraktna – ona je svuda oko nas. I na nama! Radićete sa pravom laboratorijskom opremom i naučiti veštine koje se koriste u istraživačkim centrima.